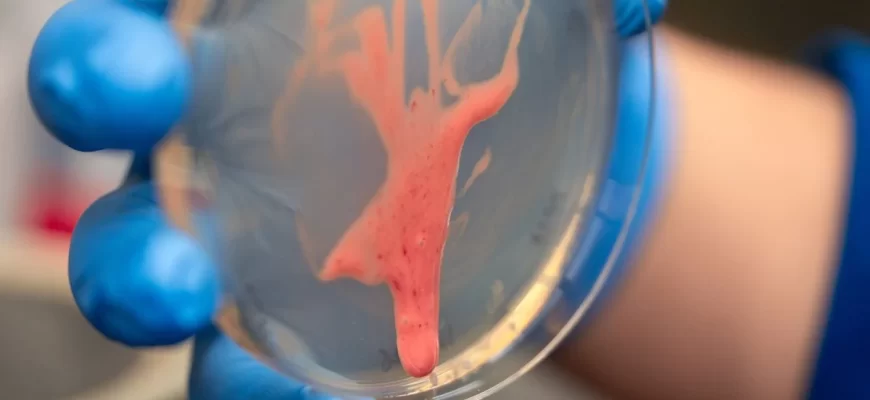

Руйнівний рослинний патоген, що роками спантеличував науковців швидкістю поширення та летальністю для врожаїв, виявився надзвичайно ефективним завдяки незвичним фізичним властивостям слизоподібної біоплівки, яка дозволяє бактеріям буквально «текти» всередині рослин.

Нове міждисциплінарне дослідження, опубліковане в журналі Proceedings of the National Academy of Sciences, об’єднало фахівців із фітопатології та інженерної фізики з Каліфорнійського університету в Девісі. Воно показує, що бактерії Ralstonia solanacearum використовують «в’язкопружну біоплівку» — матеріал, який поєднує властивості рідини й еластичного тіла, щоб швидко поширюватися по судинній системі рослин.
Особливу небезпеку становить здатність Ralstonia тривалий час виживати в ґрунті без симптомів, а після інфікування миттєво колонізувати «ксилему» — водотранспортну тканину рослин, фактично блокуючи її зсередини. «Моя аналогія полягає в тому, що вони викликають серцевий напад у рослин», пояснює Тіффані Лоу-Пауер, доцентка фітопатології UC Davis, підкреслюючи раптовість і незворотність ураження.
Ключовим чинником патогенності виявився екзополісахарид EPS-1 — довголанцюгова цукроподібна молекула, що формує біоплівку бактерій. На відміну від типових бактеріальних біоплівок, які здебільшого виконують захисну функцію, EPS-1 створює надзвичайно текучу, «слизову» структуру, здатну легко деформуватися під дією зсувних сил усередині рослинних судин. «Ралстонії харизматично огидні — у них справді є щось дуже липке», зазначає Лоу-Пауер.
Щоб зрозуміти механізм дії цієї «гидоти», до роботи залучили Харі Манікантана, інженера-фізика, який досліджує «в’язкопружність» — поєднання в’язкості (здатності текти) та еластичності (здатності відновлювати форму). Високоточні вимірювання показали, що біоплівка Ralstonia легко тече під навантаженням, характерним для руху рідини в ксилемі, що радикально прискорює поширення бактерій по всій рослині.
Подальші тести продемонстрували, що така властивість не є універсальною серед бактерій. Аналіз експериментальних даних і публічних геномів показав, що EPS-1 є унікальним саме для рослинних патогенів, пов’язаних із в’яненням. Це означає, що здатність «текти» є не побічним ефектом, а еволюційно сформованим механізмом патогенності.
Для біології це дослідження пояснює, чому Ralstonia настільки руйнівна для сільськогосподарських культур. Для фізики та інженерії воно відкриває нову модельну систему для вивчення м’якої матерії, властивості якої визначаються генетикою. «Тепер ми маємо змінну, керовану генами, яку можна математично моделювати», підсумовує Манікантан, наголошуючи на значенні роботи далеко за межами фітопатології.
#Липкий #слиз #що #вбиває #врожаї #розгадка #аграрної #катастрофи
Source link